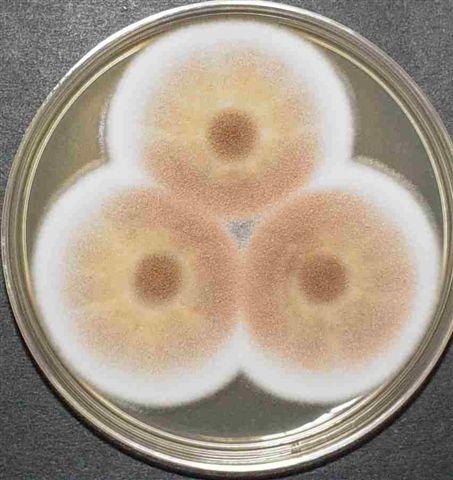
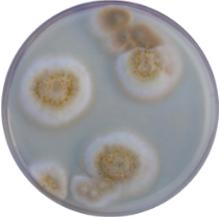

Грибы рода вешенка значительно реже поражаются вредителями и болезнями по сравнению с другими видами грибов. Основными мерами борьбы должны быть профилактические. Эти меры заключаются, прежде всего, в тщательном удалении всех источников распространения вредителей и болезней, как перед закладкой субстрата, так и в процессе дальнейшего ухода за культурой.
Настоящее руководство содержит в себе наиболее часто встречающиеся проблемы, их вероятные причины и эффективные решения. Комбинация решений обычно может решить проблемы, причины, возникновения которых порой невозможно диагностировать. Быстрее всего это можно предотвратить, решая проблемы процесса обработки, перепроектирования помещений, усовершенствования обслуживающей гигиены или замены персонала. Наиболее важно - это умение культиватора правильно оценить ситуацию и повлиять на нее.
Культиваторы должны обратить внимание, что одна ошибка может стать причиной многих проблем.
Например, повышенная влажность во время роста плодовых тел. Если в вырастной камере сохраняется повышенная влажность 100%, поверхность грибов становится влажной и является оптимальной средой для паразитических грибов и бактерий. Бактериальная плесень нападает на развивающиеся грибы. Распространяется зеленая плесень. Клещи питаются спорами плесневых грибов. Мухи разносят клещей и споры. Если эти организмы распространятся во время развития примордий, последует массовая деформация плодовых тел и заражение блоков. Те блоки, которые выживут, имеют очень короткие жизненные циклы после первой волны плодоношения. Таким образом, одна проблема - влажность - порождает массу патологических признаков.
Вывод: что хорошо для одного патогена, то хорошо для многих!
Управление микроклиматом заключает в себе следующее: создаем окружающую среду более благоприятную для роста грибов, чем конкурентов. Популяционные взрывы грибных мушек и комариков поражают гриб Вешенка больше, чем любой другой конкурент. Меры по удалению мушек применяют разные: от простых липких лент до использования химических веществ. К использованию последних следует относиться предельно осторожно. Использование химических препаратов оказывается полностью ненужным при проведении сбалансированных профилактических мер. Есть несколько биопрепаратов, успешно используемых для предотвращения зрелости мух.
Ловушки для клопов должны быть размещены возле каждой двери при входе. Я считаю, что лучшей ловушкой для клопа является та, которая имеет вид бледно-черного круга и центральнорасположенный вентилятор, создающий отрицательное вихревое давление, которое очень расширяет эффективность их применения. Под эти ловушки могут также прикрепляться липкие ленты “мухоловки”.
После сбора урожая на блоках не должно оставаться пеньков от гроздей, старых засохших грибов и примордий. Чтобы не допустить попадание насекомых через вентиляционную систему, приток свежего воздуха должен производиться через грубый фильтр.
| Проблема | Причины |
| ГРИБНЫЕ БОЛЕЗНИ | |
| 1. Зеленая плесень Trichoderma, Penicillium, Aspergillus и др. |
|
| 2. Несовершенные грибы Alternaria, Cladosporium Arthrobtrys, Sclerotium и др. |
|
| 3. "Волосатая" плесень Trichurus spirales |
|
| 4. Навозник Coprinus |
|
| 5. Коричневая плесень Chromelosporium fulvum (плодовое тело - Peziza ostracoderma) |
|
| 6. Бактериоз |
|
| 7. Розовая плесень Neurospora |
|
| 8. «Войлочная плесень» - Rizopus |
|
| СУБСТРАТНАЯ КУЛЬТУРА (стадия заращивания блоков и выращивания грибов) | |
| 7. Зоны отсутствия вегетативного роста на блоке субстрата |
|
| 8. Не начинается формирование плодовых тел |
|
| 9. На субстратных блоках растут уродливые грибы |
|
| 10. Вторая и третья волны дают малый урожай или не плодоносят вовсе |
|
| 11. Шляпки с растреск-ивающимися краями, чешуйчатые, легкие, почти белого цвета |
|
| 12. Грибы формируются, но ножки длинные, а шляпки слаборазвитые |
|
| 13. Большое количество грибов, но не все развиваются. На одном сростке 2-3 нормально развитых плодовых тела по краям и множество усохших зачатков в центре |
|
| 14. Коралловидные плодовые тела с зачаточными шляпками, ориентированные в сторону источника света |
|
| 15. Мешки, давшие первую волну, не в состоянии выдать последующие волны |
|
Обработка проводится до заполнения КК грибными блоками.
Окуривание формальдегидом:
стены и пол промывают 1% раствором гипохлорита натрия (хлористой щелочью), затем проводят окуривание формальдегидом - на 100 куб. М. Помещения необходимо 2 л. 40% формалина и 400г. Хлорной извести. Сначала 400 г. Хлорной извести помещают в открытые фарфоровые или эмалированные емкости. Посуду ставят на пол и туда доливают 2 л формалина, в результате химической реакции получают газ формальдегид. Дверь закрыть на 2 суток, потом проветрить в течение 3-4-х дней.
Окуривание сернистым газом: расставить противни на кирпичи положить в них серу из расчета 40-60г на 1куб помещения. Серу зажечь и двери плотно закрыть на 2-ое суток (если сухое помещение). Проветривать 10 суток.
Опрыскивание 2-4% раствором хлорной извести. Хлорную известь растворить в небольшом количестве воды, затем довести до указанной концентрации 2-4% и настоять 2 часа. Взболтать полученную жидкость и употреблять для опрыскивания.
Опрыскивание раствором формалина. Раствор готовят из расчета 0.25л 40% формалина на 10л. Воды, на 100 куб. помещения требуется 20л. Раствора. (На один куб помещения нужно 8-10л на 1 раз). После опрыскивания помещение закрыть на 2-ое суток.
помещение окуривают препаратами: монофос, нагос из расчета 800г на 1000куб воздуха. После окуривания помещение закрыть на 2-4 часа, затем тщательно проветрить. Через 7-8 дней дезинфекцию повторить.
Монофос и нагос сильные яды - работать с ними осторожно.
Для полива проходов использовать 2% водный раствор формалина.
Вешенка особо чувствительна к дезинфицирующим препаратам, поэтому перед загрузкой КК, помещение следует тщательно проветривать.
Конкурентная микрофлора представлена двумя группами организмов: 1) бактерии, 2) грибы. Бактерии выделяют токсичные метаболиты, которые ингибируют рост мицелия вешенки. В блоках инокулированного субстрата такие зоны обычно хорошо видны, особенно на фоне белого заросшего мицелием вешенки субстрата это достаточно четко отграниченные темного цвета зоны. Бактериальная инфекция часто встречается при выращивании мицелия вешенки на зерновом субстрате. В этом случае бактериоз проявляется также в виде отдельных, не зарастающих мицелием вешенки зон, зерно осклизлое и неприятно пахнущее. Бактериозы появляются в случае переувлажнения субстрата, недостаточной термообработки или несоблюдении оптимального температурного режима инкубации субстрата.
Конкурентные грибы представлены в основном низшими грибами - плесенями, однако, встречаются и представители высших, шляпочных грибов это виды навозников - Coprinus spp.
Плесневые грибы условно разделяют на слабо конкурентные и сильно конкурентные. Однако слабо конкурентные плесени в определенных условиях также могут приносить большой вред. Плесневые грибы поглощают питательные вещества субстрата, в первую очередь легкодоступные соединения, они также выделяют токсины, ингибирующие рост мицелия вешенки, кроме того, отдельные агрессивные биотипы, например триходермы, проявляют микопаразитические свойства.
Встречаемость различных видов конкурентных грибов зависит от места заготовки сырья, вида сырья и санитарной обстановки на самой грибной ферме. В последние годы зеленая плесень, вызываемая триходермой, постоянно представляет опасность для грибоводческих ферм, выращивающих как вешенку, так я шампиньон. В Северной Америке распространен агрессивный штамм Trichoderma harzianum - Тh-4. а в Европе - Тh-2. В Канаде около 60% шампиньонниц инфицировано биотипом Т4. Trichoderma harzianum (шгамм Тh-4) вызывает большие потери урожая вешенки на соломистом субстрате.
Конкурентные грибы на субстрате для культивирования вешенки.
| Виды грибов | Частота обнаружения | Основные причины появления |
| Trichoderma spp. (зеленая плесень) | *** | Плохая пастеризация. Температура в субстрате выше 300°С |
| Coprinus spp. (новозник) | *** | Избыток азота (СI<30) Температура в субстрате выше 30°С |
| Trichurus spirales („волосатая“ плесень) | *** | Плохая стерилизация |
| Neurospora sitophila (оранжевая плесень) | *** | Стерилизация субстрата Часто источник - мицелий |
|
Cladosporium spp. Arthobotrus spp. Sclerotium spp. |
** ** ** |
Плохая пастеризация Наличие легкодоступных питательных веществ |
| Репiсillium spp. Mucor spp. Aspergillus spp. Alternaria spp. |
* * * * |
Плохая пастеризация Наличие легкодоступных питательных веществ |
На первой волне плодоношения потери от зеленой плесени могут составлять 65%, а на второй волне 99% урожая. В среднем потери составляют 70% общего урожая. Грибные фермы, выращивающие и шампиньон, и вешенку, имеют двойной риск распространения этого агрессивного штамма по сравнению с фермами, культивирующими один вид.
Накопление конкурентной микрофлоры происходит при неправильном, открытом хранении сырья, нарушении санитарно - гигиенических норм, нарушении термического режима обработки, избыточном количестве легкодоступных соединений углерода и азота.
Конкурентная микрофлора.
| Группа | Причина накопления | Меры борьбы |
| Слабо конкурентная: Alternaria Mucor Fusarium Aspergillus Coprinus Репiсillium Сильно конкурентная: Trichoderma Gilmaniella Neurospora |
|
|
Обследование грибных ферм показало, что накопление агрессивной конкурентной микрофлоры начинается сразу же после начала работы фермы. Фактически грибоводческая ферма является новой открытой нишей для развития конкурентных организмов. Здесь есть все: тепло, влага, питание. Поэтому борьба с инфекцией должна быть на ферме постоянной и жесткой. Инфекционные Споры (пропагулы) триходермы обнаруживаются практические во всех местах инфицированной фермы (табл. 4). Концентрация спор триходермы выше в производственной зоне, где они переносятся с механизмами, персоналом или органическими остатками. На многих фермах для отдельных операций создают специальные рабочие группы, которые не пересекаются в течение рабочего дня, например группа сборщиков грибов и группа посева мицелия и фасовки субстрата. Органические отходы почва, пыль и вода на дорогах - могут быть резервуарами триходермы (табл. 5). Основная стратегия контроля развития триходермы на ферме – ограничение, локализация мест развития плесени и предотвращение ее распространения. Меры борьбы - это в основном профилактика в виде регулярных санитарно - гигиенических мероприятий
Распределение триходермы: на ферме (процент проб с биотипом Тh-4)
| Строение фермы | Чистая зона | Грязная зона |
| Внутри строений | 16.2 | 1.8 |
| Снаружи строений | 35.4 | 14.3 |
Источники инфицирования триходермой
| Материал на ферме | Процент проб с биотипом Тh-4 |
| Почва, грязь | 30.8 |
| Вода (лужи) | 20.0 |
| Органические отходы | 14.3 |
| Воздух | 13.8 |
| Пыль, сажа | 12.5 |
| Исходное сырье | 0 |
1. Зеленая плесень

Aspergillus_flavus

Aspergillus puniceus

Penicillium


Penicillium notatum


Trichoderma



2. «Волосатая» плесень

3. Навозник



4. Бактериоз

5. Розовая плесень

Neurospora

6. «Войлочная» плесень

Rhizopus

Взрослые представители достаточно маленькие в размере (2-3 мм), очень хрупкие создания, цветом от серого до черного с длинными ножками и нитевидными усиками-антенками. Крылья прозрачные или дымчатые, без какого либо узора, лишь с несколькими отдельными венами. Личинки прозрачные или слегка кремово-белые, могут вырастать до длины 6 мм. Головки личинок представляют собой маленькие блестящие капсулки.
Места, в которых был поврежден мицелий после сборки очередной волны очень притягивают этих мошек, а их личинки живут прямо на грибном мицелии, поедая его, прогрызая длинные тоннели в плодовых телах грибов. Те участки ткани гриба, которые были поражены мошками часто заселяются бактериями, что приводит к загниванию и усугублению проблемы. Взрослые особи могут также переносить споры или вирусы, например Verticillium, Mycogone и паутинной плесени.
Грибные мухи


Галлицы


Грибные комарики


Много различных видов клещей обитает в соломе и навозе, причем большая часть этих друзей полезна при выращивании, потому что живет за счет поедания различных червей и других клещей, хотя некоторые виды клещей все-таки могут причинить некоторый ущерб вашей плантации. Клещи, как и личинки мух, могут жить питаясь мицелием и плодовым телом гриба; пораженные клещем участки гриба обесцвечиваются. Так же клещи могут поедать другие низшие грибы и плесени. Один из примеров - клещ-пигмей Pymephorus spp. Эти клещи обычно сосуществуют рядом с Penicillium и триходермой, которыми они и питаются. Этот клещ не повреждает пластинчатые грибы и обладает возможностью превращаться в переходную форму, названную "гипопус". В таком состоянии клещ становится плоским и у него появляется присоска, которой он цепляется за движущиеся мимо него объекты, например, мух. В таком состоянии этот клещ обычно присутствует на верхушке гриба.
1. Клещ земляничный (Tarsonemid spp)
Эти клещи светло-коричневые, и они настолько миниатюрные, что разглядеть их можно лишь при помощи микроскопа. Они опасны тем, что поедают гифы грибницы и грибовод обычно узнает о присутствии этих организмов по характерному красно-коричневому изменению окраски основания ножки гриба. В запущенных случаях гриб отваливается у основания. Методы профилактики очевидные - следует прогревать компост при пастеризации до критических температур, для того, чтобы убить возможных клещей в субстрате. Следует тщательно очищать все поверхности от остатков грибной ткани после сбора очередной волны.

2. Амбарный клещ Tyrophagus spp.
Этих можно опознать по их медленному передвижению, прозрачности и ворсинкам на теле. Если этих клещей будет слишком много, они могут начать проедать маленькие ямочки на шляпках и ножках. Эти ямочки затем разрастаются в серьезные проблемы, потому что бактерии , которым не по зубам внешняя оболочка гриба, легко разлагают поврежденную ткань. Это приводит к тому, что кожица в таких местах сжимается , образуя глубокую яму или даже сквозное отверстие. Амбарный клещ так же может поедать мицелий грибов, и в тех местах, где этого клеща много, обычно наблюдается уменьшение урожайности. Клещи обычно попадают в субстрат с мухами-сцириадами, уже, будучи взрослыми. Мухами они обычно начинают разносится в тех случаях, когда популяция клещей становится поистине огромной. Клещи не должны являться серьезной проблемой, если при приготовлении компоста были соблюдены температура и время компостирования, и производилось нагревание до критической температуры. Следует избавляться от органических остатков рядом с субстратом - это идеальное место для размножения клещей.

3. Карликовый клещ (Pygmephorous spp)
Эти клещи не должны являтся проблемой сами по себе , но вообще их наличие свидетельствует о том, что в субстрате может быть триходерма (зеленая плесень). Эти клещи не едят грибы, но едят различные зеленые плесени. Желто-коричневые, плоскотелые , в размере всего в четверть миллиметра , и они могут размножаться с потрясающей скоростью. Живут на грибах, могут переносить споры триходермы и других зеленых плесеней.


Заказ обратного звонка
Заказ обратного звонка
Мы перезвоним вам в ближайшее время!
А пока что можете почитать наш блог! Там масса полезной информации)
В БЛОГ